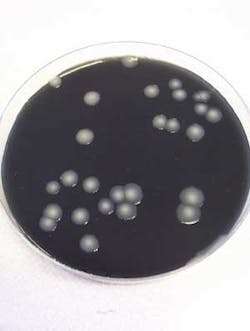
Th 0805wwigreater03 Th 0805wwigreater03

Greater Vigilance Needed for Legionella
A European lab specialist sees a growing number of water samples test positive for Legionella bacteria and is leading calls for measures to halt a rise in Legionnaires’ disease outbreaks.
Kevin Woolnough, a Legionella expert and UK-based analytical service manager at Eurofins Environmental Services, explains that whilst most people have heard of Legionnaires’ disease, few know the measures that would reduce the likelihood of outbreaks.
Last year in England and Wales, there were about 540 cases of Legionnaires’ disease with a mortality rate of 8% (see Figure 1). In more susceptible groups, this rate is thought to be in excess of 30%. Most cases were in males over 40 years old. Some 60% of cases are regarded as community acquired, as opposed to hospital acquired (~1%) or travel associated (30% abroad, 10% UK).
In Britain, Legionnaires’ disease has been most commonly associated with hot and cold water systems in large buildings, such as hospitals and hotels, and infections are usually sporadic as opposed to outbreaks with large numbers of people affected. Historically, outbreaks are associated with wet evaporative condensers (cooling towers), but increased controls have reduced incidences.
Legionellosis is the general term used to describe all forms of infection caused by bacteria of the genus Legionella, of which the most severe form is Legionnaires’ disease. Well publicised examples this year include an outbreak on the Black Watch cruise liner which affected seven elderly people; 80 prisoners were evacuated from a Kent jail as a precautionary measure; and in a Sunderland health club up to 115 people may have been affected with Legionella-like symptoms.
Household plumbing systems have also been implicated in sporadic cases of Legionnaires’ disease. In one UK study, legionellae were isolated from about 15% of the homes of affected patients in comparison with around 5% of homes in a control group.
Legionnaires’ disease develops in a relatively small proportion of those people exposed to legionellae, and the incubation period is usually about 2-10 days but can be up to16 days. Symptoms begin abruptly, ranging from a mild cough and fever to stupor, respiratory failure and multi-organ failure.
Legionella occurs naturally in low numbers in the aquatic environment lakes, rivers, surface and ground waters, and since mains water is derived from these sources it can provide a source of contamination to the built environment providing favourable conditions in which legionellae can grow rapidly (see Figure 2).
If a water droplet contains a single bacterial cell, the droplet will rapidly evaporate to a particle size diameter or droplet nucleus of about 1 μm. A particle of this size can remain suspended in air for prolonged periods of time and travel over considerable distances. These particles are dry and contain no free moisture and when air is inhaled into lungs, about 50% of the particles, of approximately 1 μm, will be retained in the lungs.
Water systems that are able produce aerosols represent the highest levels of risk. Aerosols can be generated very easily when the water surface is broken for example, by falling water droplets, splashing, or by bubbles breaking at the surface.
Once introduced to artificial water systems, Legionella can thrive in warm water (30-35°C). Urban environmental isolates are commonly detected in waters collected from air conditioning cooling towers, evaporative condensers, taps, showers, hot water tanks, fountains, spa pools, machine tools, humidifiers, car washes and on the inside surfaces of shower heads. They’ve also been shown to be present on flexible seals and metal surfaces within plumbing systems used in domestic potable water supplies.
Inadequately maintained spa pools provide ideal conditions to support the growth of legionellae and other microorganisms, which may then become aerosolised and subsequently inhaled. This was recently highlighted by the Health Protection Agency (HPA) in a warning against reliance on normal microbiological tests to indicate adequate spa maintenance. The HPA found that over 25% of pools passing current accepted levels of bacteria contained Legionella. It identified 27 cases of Legionnaires’ disease associated with spa pools in 2003, three of which were fatal.
Legionella pneumophila can survive for prolonged periods of time in tap water but don’t grow or multiply unless supported by other organisms and for this reason Legionella infection is often associated with other forms of contamination. Legionellae, if present within protozoa, can multiply and may be protected from normal concentrations of chlorine and/or other disinfectants commonly used to treat potable water supplies. Hence legionellae may be present in potable water that might appear to retain an adequate level of disinfection.
Whilst L. pneumophila has been isolated from water at temperatures ranging between 7-58°C, the bacteria only multiply actively between 20-45°C. A minimum temperature of 60°C is required to kill Legionella bacteria in hot water systems (the higher the temperature the shorter the required contact time); however, Woolnough warns, “Whilst such temperatures may sound achievable, in practice, they’re much harder to create; some calorifiers have temperature control valves that may prevent high temperatures. Furthermore, it is necessary for heat to penetrate all areas and achieve a contact time sufficient to kill the bacteria, but dead-legs, areas of poor flow and thermostatic control valves may prevent the disinfection of areas most at risk”.
In addition to water temperature, the materials and design of plumbing systems also seem to play an important role in the growth of these organisms. For example, the presence of nutrient sources such as plasticisers in synthetic rubber gaskets, plastic pipes and hoses, and the presence of dead-legs or blind-ends can support the growth of legionellae, as can obstructions to, or stagnation in, water flow.
It’s necessary for materials in contact with water to pass the appropriate materials testing analysis. Materials that haven’t been approved, however, have been known to enter the market place. In addition, the presence of biofilms or slime layers containing other background bacteria, protozoa, and algae on the surface of pipes contribute to the growth of these organisms.
In order for susceptible individuals (the elderly, smokers, patients recovering from surgery or taking immunosuppressive drugs, and people with lung disorders) to contract the disease, there must be a chain of infection. In the case of Legionella, the links in the chain are: a source of the bacteria, a reservoir or place for it to grow, a means of transmission, and a susceptible host.
The source could be any aquatic environment and the growth reservoir could be almost anywhere within water transmission/plumbing systems where it can Dry Solids Processing Made Better by Design form biofilms and multiply amongst dirt and scale.
To cause infection, Legionella normally need to be inhaled. Inhaled particles should be small enough to penetrate down to the deepest part of the lungs but large enough to contain at least one bacterial cell. These particles can remain suspended in air for prolonged periods of time. A suspension of such particles in air is termed an aerosol, and may not necessarily be visible or even wet. It’s a common misconception that a water spray is an aerosol and that legionellae have to be contained within a wet droplet. A mist of water droplets may constitute an aerosol if the droplets are small enough; however, water evaporates from small droplets very quickly.
Effective prevention and control measures must therefore break this chain and, Woolnough says, “Laboratory testing is key to the successful appraisal of risk levels and subsequent control strategy.”
The HSE’s “Approved Code of Practice and Guidance” for “The control of legionella bacteria in water systems” (commonly refereed to as “L8”) emphasises the need for risk assessments and proper maintenance of water systems. L8 advises that laboratory testing for Legionella is required when it’s known that control measures (such as temperature) are compromised, and in special cases where vulnerable people are at risk (such as in hospitals or when there’s a suspected outbreak of Legionnaires’ disease).
The frequency of testing is determined by the risk assessment. Still, Woolnough recommends, “Control measures should be verified by laboratory analysis of water samples, rather than as a result of adequate maintenance. Even well maintained systems are occasionally culture positive for Legionella; detection can sometimes highlight a problem in the system that had not previously been recognised. The frequency of subsequent testing can then be based on the verified success or otherwise of the maintenance schedule”.
Larger and older buildings represent a higher level of risk. Hospitals, colleges, care homes, offender institutions, civic centres, blocks of flats and apartments are of particular concern. Hospitals for example, tend to have more complicated plumbing, often because of additions or replacements at various stages in their history. This can lead to dead-legs, long pipe runs, cross connections, and cold water pipes that are warm as a result of the warm hospital environment. Under these circumstances it can be difficult to disinfect adequately with high temperature or chemicals; a situation that’s exacerbated by the fact hospitals need to operate 24-hours-a-day, 7-days-a-week.
Many colleges have their water systems checked for Legionella outside of term time because it’s convenient. This is a period when water usage is low and therefore the risks of stagnation and bacterial growth are higher. It’s therefore not unusual to isolate the bacteria from these systems. And whilst young people are less susceptible to Legionnaires’ disease, facilities managers and head teachers prefer to minimise the potential threat by performing an assessment and undertaking any preventative measure that may be necessary.
In addition to laboratory analysis, Eurofins also provides help and guidance on sampling and Woolnough warns: “Good quality sampling is vitally important if an accurate measure of infection is to be derived”. Samples should be as representative as possible and should undergo as little change as possible before analysis.
Sample transportation and storage should be correctly controlled; sampling point location should be appropriate; consideration should be given to the possible presence of biocides or the need for disinfection of the sample point (chlorine is a common biocide and as such the sample bottles should contain thiosulphate as a neutralising agent). Other factors include the location and timing of the sample in relation to the normal operating conditions and control measures of the system, including the timing and levels of biocide dosing, and the type and quantity of sample to be collected.
When sampling, Woolnough advises, “It is not necessary to sample at every possible point within a building; it should however, be possible to demonstrate that the samples reflect an accurate picture of the system under test. Typically, one would sample each calorifier (which may be the closest hot water tap) and the furthest hot tap, and each cold water tank together with the nearest and furthest cold water taps. If showers are present, a representative number would be sampled. If samples are found to be positive for Legionella, L8 gives guidance on appropriate actions, based on the bacteria counts and the proportion of positive samples in a system”.
Conclusion
In summary, Kevin Woolnough believes that a greater awareness of the process by which Legionella infection takes place will lead to more widespread action to reduce the number of positive results being produced in the Eurofins laboratories. Adding, “If people understand this process, they will realise that simple prevention and maintenance procedures can dramatically reduce the level of risk.”
Eurofins Environmental Services, of Kraainem, Belgium, is a leading global group of laboratories providing a range of testing and support services to the environmental, pharmaceutical, food, and consumer products industries and to governments. Contact: www.eurofins.com